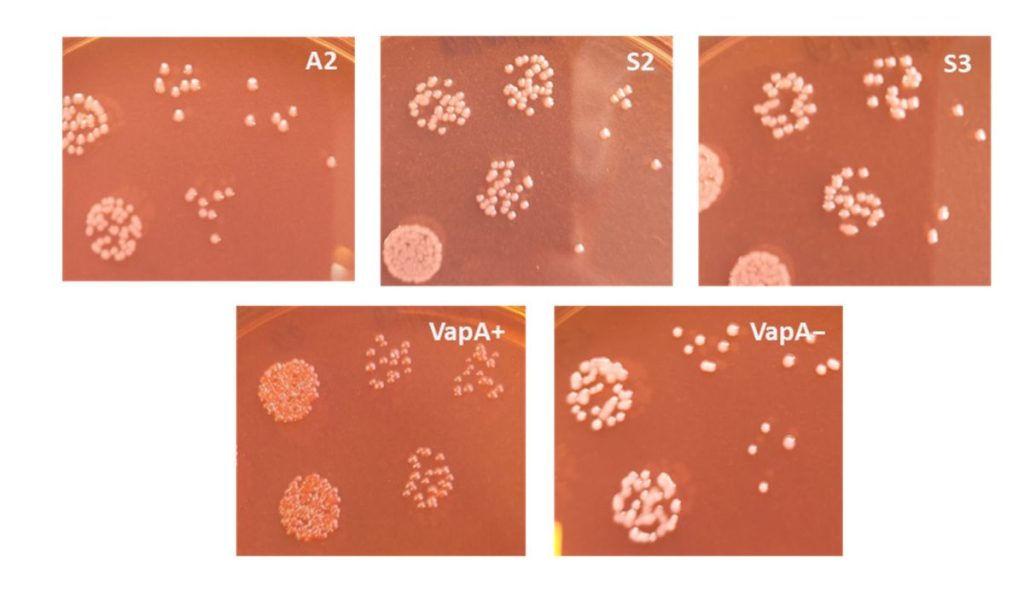

Un estudio científico reportó por primera vez en Chile la detección de Aeromonas piscicola como agente bacteriano asociado a cuadros tipo furunculosis en salmón Atlántico, un hallazgo que añade complejidad al escenario sanitario de la salmonicultura nacional en fase de agua dulce.
La investigación fue desarrollada por ADL Diagnostic Chile y TEKBios Fish Trial Center, con la participación de Marcos Mancilla, Adriana Ojeda, Yassef Yuivar, Maritza Grandón, Sebastián Valderrama, Marcela Oyarzún, Horst Grothusen, Pablo Ibarra y Patricio Bustos.
Desde ADL Diagnostic Chile, el director del Área de Investigación y Desarrollo, Marcos Mancilla, señaló que el estudio corresponde a la publicación preliminar de una investigación sobre un patógeno reportado por primera vez en Chile, identificado como Aeromonas piscicola, agente bacteriano asociado a cuadros tipo furunculosis en salmones.
Hallazgos
Publicado en Pathogens, el estudio combinó análisis genómicos, caracterización fenotípica, ensayos de virulencia in vivo y evaluación de respuesta inmune en campo para identificar el rol de este patógeno en brotes recientes de cuadros “furunculosis-like” registrados en Chile. Los resultados confirmaron que aislamientos inicialmente similares a Aeromonas salmonicida correspondían en realidad a Aeromonas piscicola, lo que constituye el primer reporte de esta bacteria en la salmonicultura chilena.
El trabajo demostró además que las cepas chilenas poseen un amplio repertorio de genes asociados a virulencia, incluyendo sistemas de secreción tipo III (T3SS), y que una de ellas mostró marcada reducción de susceptibilidad a oxitetraciclina, uno de los antibióticos utilizados en la industria. En ensayos experimentales en salmón Atlántico, una de las cepas evaluadas provocó mortalidades superiores al 80% bajo dosis altas, con lesiones cutáneas hemorrágicas y septicemia sistémica compatibles con cuadros tipo furunculosis.
Asimismo, la investigación evidenció que la vacuna actualmente utilizada contra furunculosis genera una respuesta de anticuerpos IgM marcadamente menor frente a A. piscicola en comparación con A. salmonicida, lo que sugiere una protección heteróloga limitada y plantea desafíos para los actuales protocolos de diagnóstico y prevención.
Desde ADL Diagnostic Chile señalaron que este hallazgo refuerza la necesidad de actualizar las estrategias de vigilancia sanitaria, considerando que parte de los casos históricamente atribuidos a A. salmonicida podrían corresponder a infecciones por A. piscicola.











Noticias relacionadas
PTI Industria Sostenible del Salmón proyecta nueva etapa estratégica
Ley Lafkenche: sectores productivos y autoridades abordaron reformas en Puerto Montt
Invermar se incorpora como nuevo asociado a SalmonChile
Mercado Blumar fue reconocido en el marco del décimo aniversario de Sello Azul
Camanchaca aumenta 10% sus ingresos en T1 pese a crisis por disponibilidad de jurel
Ministro del Trabajo encabeza jornada en Puerto Montt y enfatiza rol estratégico de la salmonicultura en el sur austral
Opinión: El reconocimiento que merecen los trabajadores del salmón
Con gran convocatoria: Sealice Partners abordó buenas prácticas contra Caligus en salmonicultura
Presidente Kast firma decreto que instituye el Día del Trabajador del Salmón